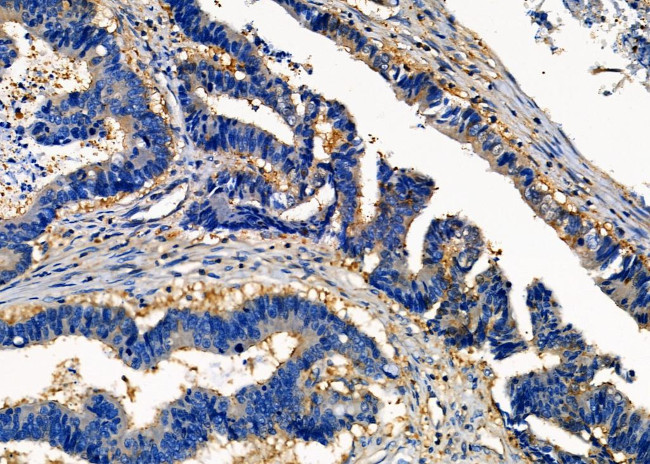
MESDC2 Antibody in Immunohistochemistry (Paraffin) (IHC (P))

Search
Invitrogen
MESDC2 Polyclonal Antibody
{{$productOrderCtrl.translations['antibody.pdp.commerceCard.promotion.promotions']}}
{{$productOrderCtrl.translations['antibody.pdp.commerceCard.promotion.viewpromo']}}
{{$productOrderCtrl.translations['antibody.pdp.commerceCard.promotion.promocode']}}: {{promo.promoCode}} {{promo.promoTitle}} {{promo.promoDescription}}. {{$productOrderCtrl.translations['antibody.pdp.commerceCard.promotion.learnmore']}}
图: 1 / 4
MESDC2 Antibody (PA5-102961) in IHC (P)




产品信息
PA5-102961
宿主/亚型
分类
类型
抗原
偶联物
形式
浓度
规格
保存条件
运输条件
RRID
产品详细信息
Antibody detects endogenous levels of total MESDC2.
靶标信息
MESDC2 chaperone specifically assisting the folding of beta-propeller/EGF modules within the family of low-density lipoprotein receptors (LDLRs). Acts as a modulator of the Wnt pathway through chaperoning the coreceptors of the canonical Wnt pathway, LRP5 and LRP6, to the plasma membrane. Essential for specification of embryonic polarity and mesoderm induction. Plays an essential role in neuromuscular junction (NMJ) formation by promoting cell-surface expression of LRP4. May regulate phagocytosis of apoptotic retinal pigment epithelium (RPE) cells.
仅用于科研。不用于诊断过程。未经明确授权不得转售。